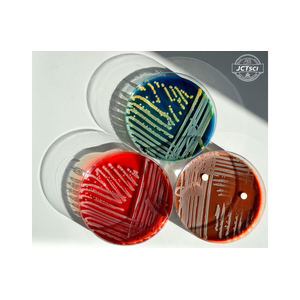

บริษัท เจ.ซี.ที. ซายน์เซอโรเก็ท จำกัด

สำนักงานใหญ่ บริษัท เจ.ซี.ที.ซายน์เซอโรเก็ท จำกัด
ที่อยู่ 267/92 ถนนสุขุมวิท ตำบลมาบตาพุด อำเภอเมืองระยอง จังหวัดระยอง 21150
เบอร์โทร 033-680-241, 081-467-9952 E-mail: jct.science@gmail.com
เวลาทำการ จันทร์-ศุกร์ 08.00-17.00 น.